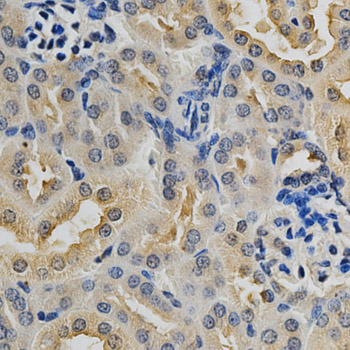

For quotations, please use our online quotation form, and you may also contact us by
service@kendallscientific.com
+1-888.733.6849 (Toll-free)
+1-617.299.7367 (Int’l))
+1-888.733.6849
Our customer service representatives are available 24 hours, Monday through Friday to assist you.| Reactivity | Human Mouse Rat |
| Tested applications | WB IHC ICC |
| Recommended Dilution | WB 1:500 - 1:2000 IHC 1:50 - 1:200 ICC 1:50 - 1:200 |
| Calculated MW | 36kDa |
| Observed MW | Refer to Figures |
| Immunogen | Recombinant protein of human MAPK10 |
| Storage Buffer | Store at -20℃. Avoid freeze / thaw cycles. Buffer: PBS with 0.02% sodium azide, 50% glycerol, pH7.3. |
| Concentration | ps |
| Synonym | FLJ12099; FLJ33785; JNK3; JNK3A; MGC50974; PRKM10; p493F12; p54Bsapk; |

Western blot analysis of extracts of various cell lines, using MAPK10 antibody.

Immunohistochemistry of paraffin-embedded human esophageal cancer using MAPK10 antibody at dilution of 1:200 (x400 lens)

Immunohistochemistry of paraffin-embedded human stomach using MAPK10 antibody at dilution of 1:200 (x400 lens)
Immunohistochemistry of paraffin-embedded mouse kidney using MAPK10 antibody at dilution of 1:200 (x400 lens)
The stress-activated protein kinase/Jun-amino-terminal kinase SAPK/JNK is potently and preferentially activated by a variety of environmental stresses including UV and gamma radiation, ceramides, inflammatory cytokines, and in some instances, growth factors and GPCR agonists (1-6). As with the other MAPKs, the core signaling unit is composed of a MAPKKK, typically MEKK1-MEKK4, or by one of the mixed lineage kinases (MLKs), which phosphorylate and activate MKK4/7. Upon activation, MKKs phosphorylate and activate the SAPK/JNK kinase (2). Stress signals are delivered to this cascade by small GTPases of the Rho family (Rac, Rho, cdc42) (3). Both Rac1 and cdc42 mediate the stimulation of MEKKs and MLKs (3). Alternatively, MKK4/7 can be activated in a GTPase-independent mechanism via stimulation of a germinal center kinase (GCK) family member (4). There are three SAPK/JNK genes each of which undergoes alternative splicing, resulting in numerous isoforms (3). SAPK/JNK, when active as a dimer, can translocate to the nucleus and regulate transcription through its effects on c-Jun, ATF-2, and other transcription factors (3,5).
N/A